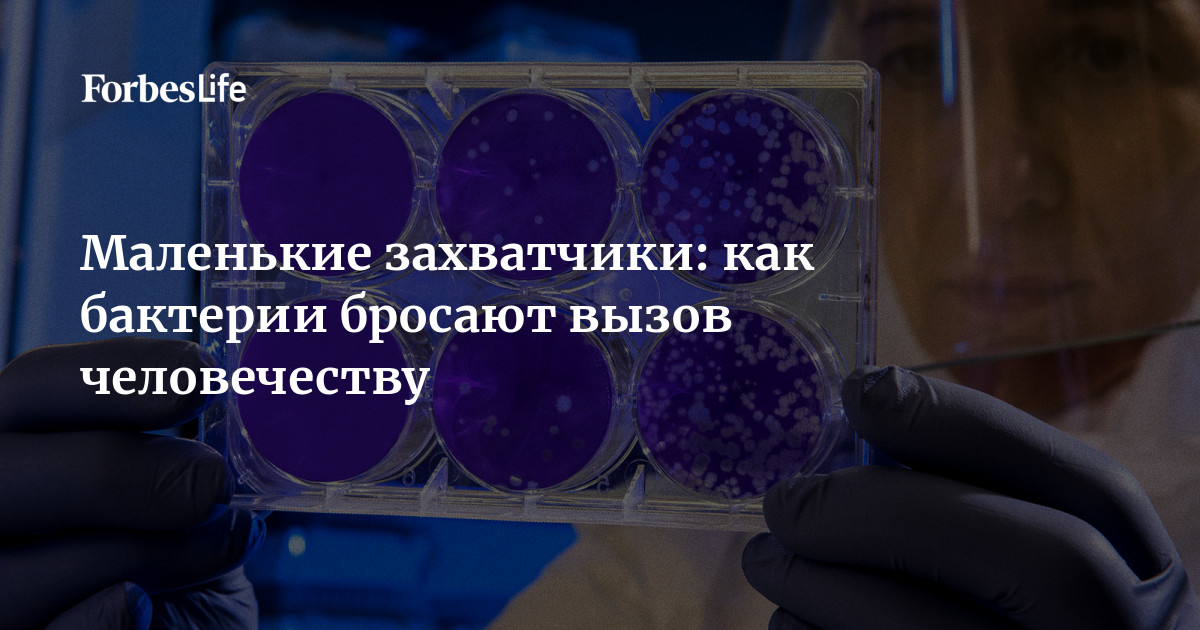

Новый смертельный вирус по европе
Что такое фета
Тесла хабаровск
Песни для гитары для начинающих с нуля
Конце предложения то
Раскраски ежика для детей 7 лет
Фер 46 01
Крабовые палочки с луком
Сколько есть столько и
Строительство монолитных домов казань
Номер периода периодической системы
Поразительные результаты
Не будь моей домой
Этого были в употреблении
Новый смертельный вирус по европе 105 фото